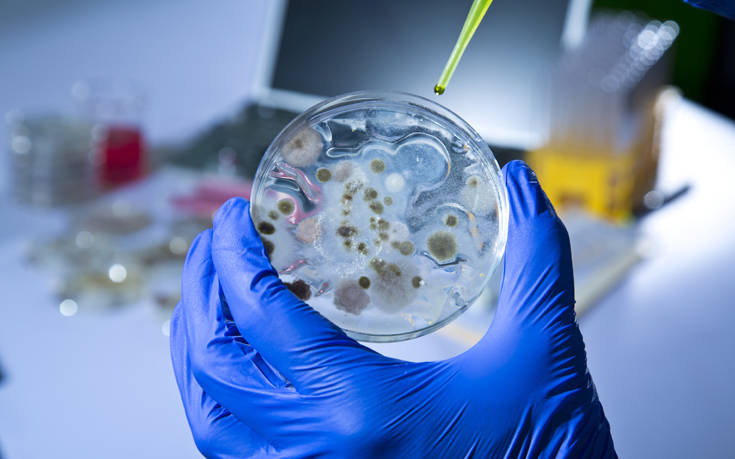

Η επιστήμη συμπλήρωσε το παζλ πώς δύο διαφορετικά στελέχη βακτηρίων μπορούν να συνδυαστούν και να σπείρουν τον όλεθρο σε έναν ασθενή, καταλήγοντας σε μια μόλυνση που τρώει το δέρμα και χρειάζεται τετραπλό ακρωτηριασμό για να σωθεί η ζωή του.
Περί πολυμικροβιακής μόλυνσης ο λόγος, ενός φαινομένου που δεν είναι ακριβώς καινούριο στην επιστήμη, καθώς συμβαίνει κάποιες φορές οι παθογόνοι μικροοργανισμοί να συνεργάζονται προκαλώντας κι άλλα προβλήματα.
Μια νέα μελέτη ανέλυσε ωστόσο το πράγμα γενετικά για να μας δείξει πώς οι μεταλλάξεις σε κάποια είδη βακτηρίων μπορούν να μεγιστοποιήσουν τη μόλυνση.
Στη μελέτη τους οι ακαδημαϊκοί του Πανεπιστημίου του Μέριλαντ και του Πανεπιστημίου του Τέξας περιγράφουν την περίπτωση ασθενούς που έφτασε στο νοσοκομείο με μια τέτοια μόλυνση που έτρωγε τις σάρκες του.
Η διάγνωση έκανε λόγο για το βακτήριο Aeromonas hydrophila, μόνο που η κατάσταση ξέφυγε από κάθε έλεγχο και η μόλυνση προχωρούσε με εκθετικούς ρυθμούς. Όταν απείλησε ευθέως τη ζωή του, προσβάλλοντας και βασικά όργανα του σώματος, αναγκάστηκαν να κόψουν και τα 4 άκρα του.
Στη μελέτη τους, που δημοσιεύτηκε στο περιοδικό «Proceedings of the National Academy of Sciences», περιγράφουν πώς ακριβώς συνδυάστηκαν τα δυο βακτήρια για να δημιουργήσουν μια κατάσταση άγνωστη στην επιστήμη.
«Η μελέτη παρέχει ξεκάθαρες ενδείξεις για το πώς μια πολύ σοβαρή μόλυνση που θεωρήθηκε πως προκαλείται από ένα είδος βακτηρίου περιείχε ουσιαστικά δύο στελέχη», λένε οι ερευνητές, «το ένα στέλεχος έδωσε μια τοξίνη που διαλύει τον μυϊκό ιστό και επιτρέπει στο άλλο στέλεχος να μεταναστεύσει στο αίμα και να προσβάλει τα όργανα»…
Η έρευνα είναι αποφασιστικής σημασίας για τον εντοπισμό της ταυτότητας των βακτηρίων σε πολυμικροβιακές μολύνσεις.